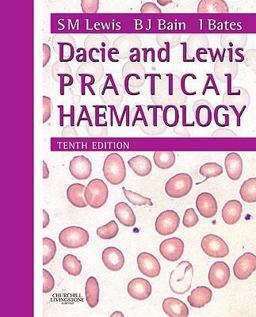
Dacie and Lewis Practical Haematology Dacie and Lewis Practical Haematology
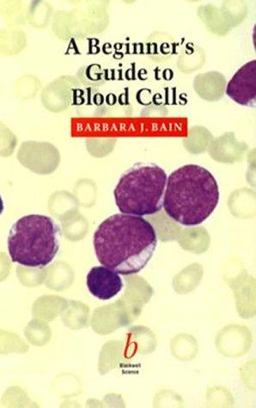
Beginner's Guide to Blood Cells Beginner's Guide to Blood Cells

More from this Author
Found 40 books by Barbara J. Bain

Haematology
by Mike Leach, Barbara J. Bain

Blood Cells
by Barbara J. Bain

Multiple Choice Questions for Haematology and Core Medical Trainees
by Barbara J. Bain

Dacie and Lewis Practical Haematology
by Barbara J. Bain, Imelda Bates, Mike A. Laffan

A Beginner's Guide to Blood Cells
by Barbara J. Bain

Haemoglobinopathy Diagnosis
by Barbara J. Bain

Bone Marrow Pathology
by Barbara J. Bain, David M. Clark, Bridget S. Wilkins

Haemoglobinopathy Diagnosis
by Barbara J. Bain, David C. Rees

Bone Marrow Pathology
by David M. Clark, Bridget S. Wilkins, Barbara J. Bain

Bone Marrow Pathology
by Barbara J. Bain, David M. Clark, Bridget S. Wilkins, Vishakha Sovani

Practical Flow Cytometry in Haematology
by Mark Drummond, Allyson Doig, Pam McKay, Bob Jackson, Barbara J. Bain, Mike Leach

Leukaemia Diagnosis
by Barbara J. Bain, Mike Leach

Haemoglobinopathy Diagnosis
by Barbara J. Bain

Immunophenotyping for Haematologists
by Barbara J. Bain, Mike Leach

Neonatal Haematology
by Irene Roberts, Barbara J. Bain

Variant Haemoglobins
by Barbara J. Bain, Lorraine Phelan, Adrian Stephens, Barbara Wild
Dacie and Lewis Practical Haematology
by Barbara J. Bain, Imelda Bates, S. Mitchell Lewis

Leukaemia Diagnosis
by Barbara J. Bain

A - Z of Haematology
by Barbara J. Bain, Rajeev Gupta

Blood Cells
by Barbara J. Bain

Blood Cells
by Barbara J. Bain

Practical Haematology
by S. Mitchell Lewis, John Dacie, Barbara J. Bain, Imelda Bates

Blood Cells
by Barbara J. Bain

Blood Cells
by Barbara J. Bain

Hematology
by Barbara J. Bain

Leukaemia Diagnosis
by Barbara J. Bain

A Beginner's Guide to Blood Cells
by Barbara J. Bain

Bone Marrow Pathology
by Barbara J. Bain, David Clark, Irvin Lampert
Beginner's Guide to Blood Cells
by Barbara J. Bain

Leukaemia Diagnosis
by Barbara J. Bain

Haemoglobinopathy Diagnosis
by Barbara J. Bain

Bone Marrow Pathology
by Barbara J. Bain, David M. Clark, Irvin A. Lampert, Bridget S. Wilkins

Variant Haemoglobins
by Barbara J. Bain, Barbara Wild, Adrian Stephens, Lorraine Phelan

Variant Haemoglobins
by Barbara J. Bain, Barbara Wild, Adrian Stephens, Lorraine Phelan

Blood Cells
by Barbara J. Bain

Interactive Haematology Imagebank
by Barbara J. Bain

Lymphoid Malignancies
by Estella Matutes, Barbara J. Bain, A. C. Wotherspoon

Haematology
by Barbara J. Bain

Blood Cells
by Barbara J. Bain, Mike Leach

Blood Cells
by Barbara J. Bain
